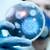

Yorgunluğunuzun sebebi Kronik yorgunluk sendromu mu?
 Son zamanlarda grip olmadığınız halde sürekli başınız ve kaslarınız ağrıyor; her fırsatta dinlenmenize rağmen bir türlü kendinizi toparlayamadığınızı hissediyorsanız Kronik Yorgunluk Sendromu yaşıyor olabilirsiniz. Birçok hastalıkla benzer özellikler gösterdiği için fark edilemeyen Kronik Yorgunluk Sendromu hakkında bilgi veren İç Hastalıkları Uzmanı Dr. Akif Nuri Doğan, en çok merak edilen soruları yanıtladı: Bir takım teoriler olsa da kronik yorgunluk sendromunun nedeni tam belli değildir. Kronik Yorgunluk Sendromu bozuk bir bağışıklık sistem yapısından meydana gelen sinir sistemi inflamasyonudur. Özellikle 30-50 yaş grubundaki kadınlarda daha fazla görülen hastalığın semptomları grip ya da diğer viral enfeksiyonlara çok benzer. Kas ağrısı, aşırı yorgunluk ve baş ağrısı en sık görülen belirtileridir. En önemli nedeni strestir.
Son zamanlarda grip olmadığınız halde sürekli başınız ve kaslarınız ağrıyor; her fırsatta dinlenmenize rağmen bir türlü kendinizi toparlayamadığınızı hissediyorsanız Kronik Yorgunluk Sendromu yaşıyor olabilirsiniz. Birçok hastalıkla benzer özellikler gösterdiği için fark edilemeyen Kronik Yorgunluk Sendromu hakkında bilgi veren İç Hastalıkları Uzmanı Dr. Akif Nuri Doğan, en çok merak edilen soruları yanıtladı: Bir takım teoriler olsa da kronik yorgunluk sendromunun nedeni tam belli değildir. Kronik Yorgunluk Sendromu bozuk bir bağışıklık sistem yapısından meydana gelen sinir sistemi inflamasyonudur. Özellikle 30-50 yaş grubundaki kadınlarda daha fazla görülen hastalığın semptomları grip ya da diğer viral enfeksiyonlara çok benzer. Kas ağrısı, aşırı yorgunluk ve baş ağrısı en sık görülen belirtileridir. En önemli nedeni strestir.
Kronik Yorgunluk Sendromu belirtileri
- En az 6 aydır ne kadar dinlenirseniz dinlenin geçmeyen bir yorgunluğunuz varsa,
- Bu yorgunluğa baş ve kas ağrıları eşlik ediyorsa,
- Günlük aktivitelerinizi kısıtlayacak kadar ağrı çekiyorsanız,
- Egzersiz sonrası 1 saat içerisinde geçecek ağrılarınız 24 saat geçse de azalmıyorsa,
- Unutkanlık ve konsantrasyon problemleri yaşamaya başladıysanız,
- Kızarıklık, şişlik gibi Artrit belirtileri olmayan eklem ağrıları çekiyorsanız,
- Sersemlik hissi yaşıyorsanız,
- 5-8 saat uyumanıza rağmen uykunuzu alamıyorsanız,
- Sese, gürültüye, ışığa, çevresel faktörlere karşı aşırı duyarlıysanız,
Dikkat! Depresyon kronik yorgunluk sendromuna neden olabilir
- Ateşiniz çok olmasa da yükseliyorsa (38,3’ten daha az olan ateş),
- Boğazınızda ağrı ve yanma varsa, hekiminize başvurmanızda fayda var. Kronik Yorgunluk Sendromu yaşıyor olabilirsiniz.
Kronik Yorgunluk Sendromu Tanı ve Tedavisi
Kronik Yorgunluk Sendromu için spesifik bir test yoktur. En az dört semptomun bir arada görülmesi gerekir. Özellikle çok uzun süreli nedensiz yorgunluk tanı koymada önemli rol oynar. Yapılan muayene ve testlerle olası sebepler dışlandıktan sonra tanısı konulan hastalığın semptomik ve kombine tedavisi gerekir. Tedavinin amacı semptomları azaltmaktır. Birçok Kronik Yorgunluk Sendromu hastasının tedavi ile düzelen depresyonu ve psikolojik bozuklukları vardır. Tedavi;
- Davranışsal terapi ve bazı hastalar için derecelenmiş egzersiz
- Sağlıklı beslenme
- Uyku yönetim teknikleri
- Ağrıyı, rahatsızlığı ve ateşi düşürecek ilaç tedavisi
- Anksiyete için ilaç tedavisi
- Depresyon için ilaç tedavisi kombinasyonunu içerir.
Kronik Yorgunluk Sendromu yaşayan hastalar aktif bir sosyal yaşam için teşvik edilir. Rahatlama ve stres azaltma teknikleri kronik ağrı ve yorgunluğu azaltmaya yardımcı olabilir, fakat bunlar Kronik Yorgunluk Sendromu için esas tedavi yöntemi değildir. Orta dereceli fiziksel egzersiz de yararlı olabilir.
Kronik yorgunluk intihara sürükler mi? Türkiye’de 15 milyon yorgun var!
Hekiminiz ne kadar aktivite yapabileceğiniz ve yavaşça bunu nasıl artırabileceğiniz konusunda size yardımcı olabilir. Eğer inatçı, sık yorgunluk hissediyorsanız hastalığın semptomları olsun ya da olmasın uzmanınızı arayın. Başka ciddi hastalıklarda benzer bulgular verebilir ve bunların dışlanması gereklidir.
Kronik Yorgunluk Sendromu ile Başa Çıkmanın İpuçları…
- Yorgun hissettiğiniz günlerde çok fazla egzersizden kaçının.
- Aktivite, dinlenme ve uyku zamanlarınız arasındaki dengeyi sağlayın.
- Büyük görevleri daha küçük yapabilir boyuta indirgeyin.
- Daha zorlu görevleri haftaya yayarak yapın.
- Derin nefes egzersizleri yapın.
YAZIYI PAYLAŞ


 Son zamanlarda grip olmadığınız halde sürekli başınız ve kaslarınız ağrıyor; her fırsatta dinlenmenize rağmen bir türlü kendinizi toparlayamadığınızı hissediyorsanız Kronik Yorgunluk Sendromu yaşıyor olabilirsiniz. Birçok hastalıkla benzer özellikler gösterdiği için fark edilemeyen Kronik Yorgunluk Sendromu hakkında bilgi veren İç Hastalıkları Uzmanı Dr. Akif Nuri Doğan, en çok merak edilen soruları yanıtladı: Bir takım teoriler olsa da kronik yorgunluk sendromunun nedeni tam belli değildir. Kronik Yorgunluk Sendromu bozuk bir bağışıklık sistem yapısından meydana gelen sinir sistemi inflamasyonudur. Özellikle 30-50 yaş grubundaki kadınlarda daha fazla görülen hastalığın semptomları grip ya da diğer viral enfeksiyonlara çok benzer. Kas ağrısı, aşırı yorgunluk ve baş ağrısı en sık görülen belirtileridir. En önemli nedeni strestir.
Son zamanlarda grip olmadığınız halde sürekli başınız ve kaslarınız ağrıyor; her fırsatta dinlenmenize rağmen bir türlü kendinizi toparlayamadığınızı hissediyorsanız Kronik Yorgunluk Sendromu yaşıyor olabilirsiniz. Birçok hastalıkla benzer özellikler gösterdiği için fark edilemeyen Kronik Yorgunluk Sendromu hakkında bilgi veren İç Hastalıkları Uzmanı Dr. Akif Nuri Doğan, en çok merak edilen soruları yanıtladı: Bir takım teoriler olsa da kronik yorgunluk sendromunun nedeni tam belli değildir. Kronik Yorgunluk Sendromu bozuk bir bağışıklık sistem yapısından meydana gelen sinir sistemi inflamasyonudur. Özellikle 30-50 yaş grubundaki kadınlarda daha fazla görülen hastalığın semptomları grip ya da diğer viral enfeksiyonlara çok benzer. Kas ağrısı, aşırı yorgunluk ve baş ağrısı en sık görülen belirtileridir. En önemli nedeni strestir. Kronik yorgunluk sendromunun bağırsak florası ile bağlantılı olduğu keşfedildi
Kronik yorgunluk sendromunun bağırsak florası ile bağlantılı olduğu keşfedildi Yorgunluk neden olur? Hangi hastalıkların belirtisidir? Ne iyi gelir?
Yorgunluk neden olur? Hangi hastalıkların belirtisidir? Ne iyi gelir? Dikkat! Depresyon kronik yorgunluk sendromuna neden olabilir
Dikkat! Depresyon kronik yorgunluk sendromuna neden olabilir Kromozomal Hastalıklar – 2: Angelman Sendromu ve Prader-Willi Sendromu
Kromozomal Hastalıklar – 2: Angelman Sendromu ve Prader-Willi Sendromu Yorgunluğunuzun sebebi bahar mı, yoksa tiroid hastalıkları mı?
Yorgunluğunuzun sebebi bahar mı, yoksa tiroid hastalıkları mı?
YORUMUNUZ VAR MI?